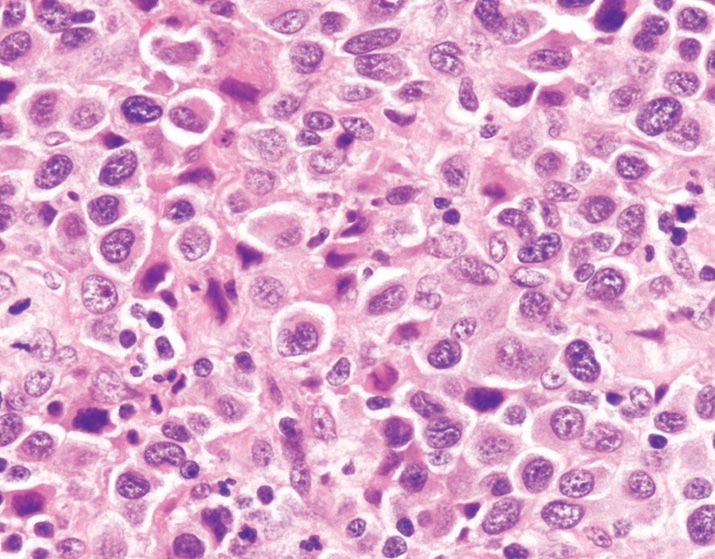
Hematopathology: Lymph Node and Spleen | Basicmedical Key

In addition to the information above, here is a curated collection of images related to Characterization Of B Cell Heterogeneity In The Spleen And Lymph Nodes.
- Characterization Of B Cell Heterogeneity In The Spleen And Lymph Nodes ...
- (PDF) Heterogeneity Of B Cell Lymphopoiesis In Patients With ...
- (A) Cells Isolated From Spleen (SP), Mesenteric Lymph Node (MLN), And ...
- Blood Endothelial Cell Heterogeneity In Murine Peripheral Lymph Nodes ...
- Phenotypic Characterization Of Splenic B Cells. Flow Cytometric ...
Find More About "Characterization Of B Cell Heterogeneity In The Spleen And Lymph Nodes"
Explore exclusive offers, detailed information, and related services about characterization of b cell heterogeneity in the spleen and lymph nodes from our trusted partners.
View Special Offers